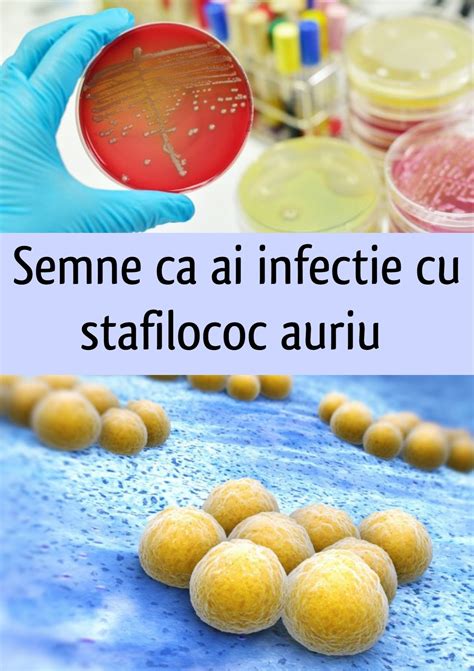
Ilustrație a diferitelor tipuri de infecții ale pielii cauzate de stafilococ auriu

Stafilococul auriu, cunoscut științific sub numele de Staphylococcus aureus, este o bacterie gram-pozitivă cu o formă rotund-ovală (coci), care se găsește frecvent în mediul înconjurător, inclusiv pe pielea și mucoasele oamenilor și animalelor. Deși adesea inofensiv în condiții normale, acesta este responsabil pentru o gamă largă de infecții, de la cele superficiale la cele grave, precum meningita sau septicemia.
Numele său, "auriu", provine de la pigmentul auriu pe care îl produce. În mod normal, această bacterie colonizează pielea și mucoasele, fiind prezentă în nasul a aproximativ 30% dintre persoanele sănătoase. Deși nu produce probleme de sănătate în mod obișnuit pe pielea intactă, pătrunderea sa în organism prin leziuni cutanate sau alte căi poate declanșa infecții.

Ce este Staphylococcus aureus?
Staphylococcus aureus sau stafilococul auriu este un agent patogen care provoacă o gamă largă de infecții stafilococice clinice. Este reprezentat de bacterii gram-pozitive cu formă de sferă, de unde și denumirea de coci. Stafilococul auriu se numără printre cele mai răspândite bacterii care cauzează probleme de sănătate la oameni. Este principala cauză a infecțiilor care apar la nivelul pielii și țesuturilor moi, cum ar fi abcesele, furunculele și celulita infecțioasă.
Bacteria care provoacă infecțiile stafilococice poartă denumirea de stafilococ auriu și se găsește peste tot în jurul nostru. Traiește inclusiv pe suprafețe și pe sol. În plus, se găsește pe piele, în nas (cunoscut în mod popular drept "stafilococ auriu în nas") și în gât (cunoscut, de asemenea, drept "stafilococ auriu în gât").
Stafilococul auriu poate fi prezent pe pielea sau în nasul tău și este posibil ca tu să nu te îmbolnăvești, dar ești un purtător, care poate răspândi infecția. După o perioadă, există riscul să dezvolți o infecție stafilococică de la bacteriile pe care le ai deja și care au ajuns în altă regiune a corpului. Te poți îmbolnăvi, însă, și de toxinele produse de bacterii.
Cum se manifestă infecțiile cu Stafilococ Auriu?
Majoritatea infecțiilor cauzate de stafilocul auriu afectează pielea și țesuturile moi, provocând abcese sau celulită infecțioasă. Celulita infecțioasă este o infecție a straturilor subiacente ale pielii. De obicei, se produce în urma unei zgârieturi sau tăieturi a pielii care permite pătrunderea bacteriilor. De asemenea, stafilococul auriu poate provoca și infecții grave, cum ar fi pneumonia (infecția plămânilor) sau bacteremia (o afecțiune caracterizată prin prezența bacteriilor în sânge).
Printre manifestările infecțiilor cu stafilococ auriu se numără:
- Impetigo: în această infecție se formează vezicule superficiale, pline cu lichid, ce provoacă mâncărime și răni.
- Necroliza epidermică toxică: este o infecție gravă a pielii identificată la bebeluși și copii mici și determină descuamarea epidermei pe suprafețe mari ale corpului.
- Infecții mamare: mastită cu celulită și abcese, înroșirea zonei din jurul mamelonului și durere intensă.
- Pneumonie: cu febră mare, dificultăți respiratorii, tuse cu spută și sânge, uneori.
- Endocardită: deteriorarea rapidă a valvelor cardiace determină insuficiență cardiacă și dificultăți respiratorii.
- Sindrom de șoc toxic: formă gravă de septicemie manifestată prin febră, dureri musculare și erupție cutanată care arată ca arsura solară.
Ce este S. aureus meticilino-rezistent (MRSA)?
Infectia cu MRSA (Staphylococcus aureus rezistent la meticilină) este cauzată de un tip de bacterie stafilococică care a devenit rezistentă la multe dintre antibioticele utilizate pentru tratarea infecțiilor stafilococice obișnuite. MRSA este un tip de bacterie care a dezvoltat mecanisme de rezistență la unele antibiotice. Infecțiile cu MRSA sunt greu de tratat deoarece foarte puține antibiotice sunt eficiente împotriva acestora.
Apariția MRSA este rezultatul unei perioade de timp îndelungate în care antibioticele au fost utilizate excesiv, inutil sau eronat în cadrul anumitor afecțiuni. Chiar și atunci când antibioticele sunt utilizate corespunzător, ele contribuie la creșterea numărului de bacterii rezistente la antibiotice, deoarece bacteriile evoluează și se adaptează, supraviețuind tratamentului cu un anumit antibiotic.
Rezistența la meticilină a apărut la Staphylococcus aureus prin mutația unei proteine care leagă penicilina. MRSA, în prezent, este rezistent la peniciline (precum amoxicilină, meticilină, oxacilină, penicilină), la cefalosporine și la carbapeneme. Stafilococul auriu meticilino-rezistent poate fi prezent în mod normal pe piele sau la nivelul cavității nazale la 2% din populație, fără a provoca nicio manifestare.
MRSA pătrunde în organism, de obicei, printr-o leziune deschisă, cum ar fi o tăietură la nivelul pielii. Cel mai frecvent, MRSA provoacă afecțiuni ale pielii, dar mai rar, poate provoca și infecții mai grave, cum ar fi răni infectate sau pneumonie. Nu toate persoanele care contactează MRSA dezvoltă infecții; unele persoane pot fi purtătoare de MRSA.

Diagnosticarea și tratamentul infecțiilor cu Stafilococ Auriu
Medicii recunosc imediat o infecție cu stafilococ auriu. Specialistul poate efectua teste pentru a alege cel mai bun antibiotic care să trateze infecția. Testele recomandate de regulă pentru depistarea infecției cu stafilococ auriu vizează analize de sânge, urină, piele - colectarea materialului infectat, secreții nazale. De asemenea, o ecocardiogramă îi va arăta medicului dacă infecția a ajuns la inimă. Uneori pot fi necesare și alte teste imagistice, precum CT.
Tratamentul afectiunilor provocate de stafilococul auriu ține cont de tipul de infecție, de prezența sau absența tulpinilor rezistente la medicamente. Când vorbim de tratamentul antibiotic, acesta poate fi administrat intravenos în cazurile mai grave, într-o primă fază, pentru ca apoi să poți continua cu pastile la domiciliu. Uneori poate fi nevoie de îndepărtarea chirurgicală a osului infectat și/sau a materialului străin, evident, la sugestia medicului specialist. Drenarea abcesului este o altă soluție pe care specialistul o va avea în vedere în unele situații.
Diagnosticul infecției cu MRSA necesită identificarea și demonstrarea prezenței bacteriei la locul infecției. Acest lucru implică prelevarea unei mostre de țesut sau de lichid de la nivelul infecției și însămânțarea pe un mediu de cultură, ce va permite creșterea bacteriei atunci când ea este prezentă.
Tratamentul infecției cu MRSA depinde de localizarea infecției. Acesta va fi, întotdeauna, unul medicamentos, pe bază de antibiotice cu spectru împotriva MRSA, putând fi completat, în anumite situații, de tratament chirurgical. De exemplu, dezvoltarea unui abces va necesita, pe lângă tratament antibiotic, tratament chirurgical prin incizie și drenaj.
Laborator Staphylococcus aureus 🧫 Diagnostic și tratament | Microbiologie și boli infecțioase
Prevenirea infecțiilor cu Stafilococ Auriu
Contactul cu stafilococul auriu nu poate fi evitat complet, însă puteți reduce riscul de a dezvolta o infecție. O bună igienă este necesară pentru asigurarea stării generale de sănătate, dar și pentru prevenirea infecțiilor stafilococice. Poate fi dificil de prevenit infecția cu stafilococul auriu deoarece oamenii poartă această bacterie pe piele.
Prevenirea răspândirii infecției se poate face prin:
- Spălarea mâinilor corect cu apă și săpun, ori de câte ori este nevoie.
- Dezinfectarea periodică a mâinilor cu soluție pe bază de alcool este o procedură benefică de restrângere a ariei infecției.
- Suflarea nasului în batiste de unică folosință, aruncarea lor imediat după utilizare și spălarea mâinilor sunt reguli de igienă de bază ce nu trebuie neglijate.
- Este interzisă atingerea plăgilor, zgârieturilor sau tăieturilor altor persoane.
- În cazul în care este necesară schimbarea pansamentului unui pacient care are infecție cutanată cu SARM, se recomandă purtarea unor mănuși de protecție.
Foarte important de știut și de urmat indicația - nu prepara și nu manipula alimente - dacă ești diagnosticat cu stafilococ auriu, pentru a nu favoriza propagarea infecției!
Stafilococul Auriu în Sarcină
În cazul în care bacteria patrunde la nivelul tegumentelor, de exemplu printr-o plagă tăiată sau leziune inflamatorie, poate produce vezicule (băşicuţe cu lichid) dureroase sau furuncule inflamatorii, cu tumefiere și puroi sau alte tipuri de leziuni exudative. Uneori, în cazul în care stafilococul pătrunde în organism, poate produce infecții severe de tipul pneumoniei sau poate întârzia vindecarea unor plăgi postoperatorii.
Nu au fost raportate cazuri de avort spontan sau naștere prematură. Existența acestor infecții nu crește riscul de a naște un copil cu defecte congenitale. Foarte multe antibiotice pot fi folosite în timpul sarcinii. Studiile au arătat că folosirea antibioticelor de tipul meticilinei în timpul sarcinii nu produce defecte congenitale asupra fătului sau a altor afecțiuni. În cazul în care ai infecție cu SARM, care nu răspunde la antibiotice de tipul meticilinei, medicul specialist va decide dacă este nevoie de schimbarea antibioticului, care dintre acestea este mai adecvat și dacă există vreun risc asupra sarcinii prin folosirea acestuia.
Alăptarea și infecția cu S. În cazul în care există infecție cu SARM și alăptezi la sân, este foarte importantă informarea medicului specialist, pentru a alege cel mai adecvat antibiotic în acest caz. Unii copii sunt alergici la anumite antibiotice. În cazul în care am infecție cutanată cu SARM, copilul meu ar putea lua infecția de la mine? Copilul alăptat la sân nu poate contacta infecția cu SARM din laptele de mamă. Cu toate acestea, copilul poate fi infectat prin contactul cu plaga infectată, secrețiile de la nivelul plăgii sau cu pansamentele, hainele, lenjeria de pat și alte materiale care au fost în contact cu plaga.

tags: #stafilococul #auriu #sarcina #electrica